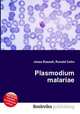
Plasmodium malariae, Jesse Russell,Ronald Cohn

Поиск книг, учебников, пособий в онлайн-магазинах
Найдено 3827822, cтраницы: ← | 1 ... 88015 88016 88017 88018 · 88019 · 88020 88021 88022 88023 ... 318986 | →
The Global Voices Program
High Quality Content by WIKIPEDIA articles! Global Voices is an international cu...
Автор: Jesse Russell,Ronald Cohn, 64 стр., издатель: "Книга по Требованию", ISBN: 978-5-5081-1617-0
High Quality Content by WIKIPEDIA articles! Global Voices is an international cu...
History of dog agility
High Quality Content by WIKIPEDIA articles! The history of dog agility can be tr...
Автор: Jesse Russell,Ronald Cohn, 137 стр., издатель: "Книга по Требованию", ISBN: 978-5-5081-1616-3
High Quality Content by WIKIPEDIA articles! The history of dog agility can be tr...
Amargosa Valley, Nevada
High Quality Content by WIKIPEDIA articles! Amargosa Valley (formerly Lathrop We...
Автор: Jesse Russell,Ronald Cohn, 113 стр., издатель: "Книга по Требованию", ISBN: 978-5-5081-1615-6
High Quality Content by WIKIPEDIA articles! Amargosa Valley (formerly Lathrop We...
Naples Central School District
High Quality Content by WIKIPEDIA articles! Naples Central School District is a ...
Автор: Jesse Russell,Ronald Cohn, 128 стр., издатель: "Книга по Требованию", ISBN: 978-5-5081-1614-9
High Quality Content by WIKIPEDIA articles! Naples Central School District is a ...
Plasmodium malariae
High Quality Content by WIKIPEDIA articles! Plasmodium malariae is a parasitic p...
Автор: Jesse Russell,Ronald Cohn, 101 стр., издатель: "Книга по Требованию", ISBN: 978-5-5081-1613-2
High Quality Content by WIKIPEDIA articles! Plasmodium malariae is a parasitic p...
University of Tartu Viljandi Culture Academy
High Quality Content by WIKIPEDIA articles! Coordinates: 58°21?59?N 25°35?50?E? ...
Автор: Jesse Russell,Ronald Cohn, 119 стр., издатель: "Книга по Требованию", ISBN: 978-5-5081-1612-5
High Quality Content by WIKIPEDIA articles! Coordinates: 58°21?59?N 25°35?50?E? ...
I'm with You (song)
High Quality Content by WIKIPEDIA articles! "I'm with You" is a song by Canadian...
Автор: Jesse Russell,Ronald Cohn, 143 стр., издатель: "Книга по Требованию", ISBN: 978-5-5081-1611-8
High Quality Content by WIKIPEDIA articles! "I'm with You" is a song by Canadian...
Lacquer
High Quality Content by WIKIPEDIA articles! In a general sense, lacquer is a som...
Автор: Jesse Russell,Ronald Cohn, 113 стр., издатель: "Книга по Требованию", ISBN: 978-5-5081-1610-1
High Quality Content by WIKIPEDIA articles! In a general sense, lacquer is a som...
Welshpool Football Club
High Quality Content by WIKIPEDIA articles! Welshpool Football Club was an Austr...
Автор: Jesse Russell,Ronald Cohn, 99 стр., издатель: "Книга по Требованию", ISBN: 978-5-5081-1609-5
High Quality Content by WIKIPEDIA articles! Welshpool Football Club was an Austr...
Anton Robert Krueger
High Quality Content by WIKIPEDIA articles! Born in Phalaborwa, South Africa on ...
Автор: Jesse Russell,Ronald Cohn, 121 стр., издатель: "Книга по Требованию", ISBN: 978-5-5081-1608-8
High Quality Content by WIKIPEDIA articles! Born in Phalaborwa, South Africa on ...
Data rate units
High Quality Content by WIKIPEDIA articles! In telecommunications, bit rate or d...
Автор: Jesse Russell,Ronald Cohn, 102 стр., издатель: "Книга по Требованию", ISBN: 978-5-5081-1607-1
High Quality Content by WIKIPEDIA articles! In telecommunications, bit rate or d...
Bettye LaVette
High Quality Content by WIKIPEDIA articles! Bettye LaVette (born Betty Haskins, ...
Автор: Jesse Russell,Ronald Cohn, 114 стр., издатель: "Книга по Требованию", ISBN: 978-5-5081-1606-4
High Quality Content by WIKIPEDIA articles! Bettye LaVette (born Betty Haskins, ...
Найдено 3827822, cтраницы: ← | 1 ... 88015 88016 88017 88018 · 88019 · 88020 88021 88022 88023 ... 318986 | →